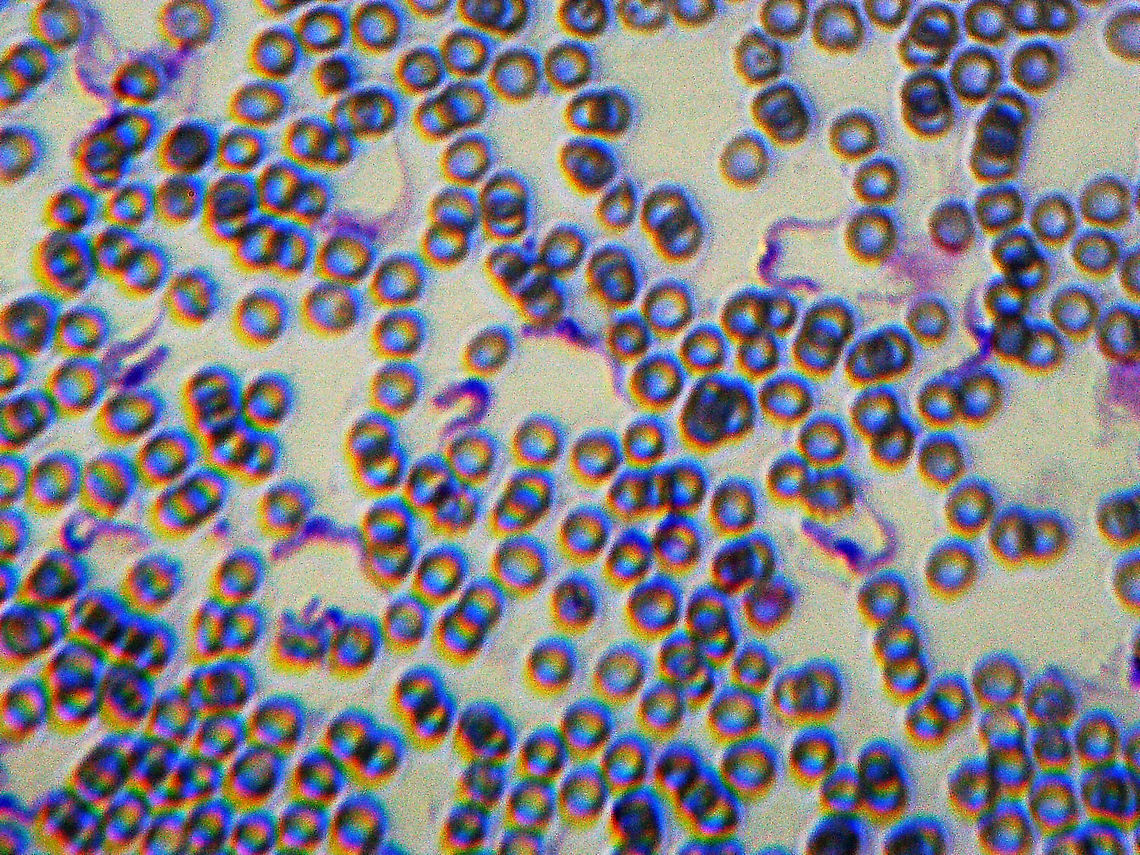

Trypanosoma brucei rhodesiense Smear
Sorry for the blurry image! This slide was so hard to focus. The squiggly bits are the protozoans: The dark part of the nematode is the nucleus and the squiggly end is the flagellum.
Trypanosoma rhodesiense is a protozoan parasite that causes sleeping sickness. This species causes acute African trypanosomiasis that is quickly deadly.
Humans can become infected by two types: Trypanosoma brucei gambiense (TbG) and Trypanosoma brucei rhodesiense (TbR). TbG causes over 98% of reported cases. Both forms are transmitted by the bite of an infected tsetse fly (Glossina sp.).

''Trypanosoma brucei'' is a species of parasitic kinetoplastid belonging to the genus ''Trypanosoma''. This parasite is the cause of vector-borne diseases of vertebrate animals, including humans, carried by species of tsetse fly in sub-Saharan Africa. In humans ''T. brucei'' causes African trypanosomiasis, or sleeping sickness. In animals it causes animal trypanosomiasis, also called nagana in cattle and horses. ''T. brucei'' has traditionally been grouped into three subspecies: ''T. b. brucei'',.. more
comments (4)